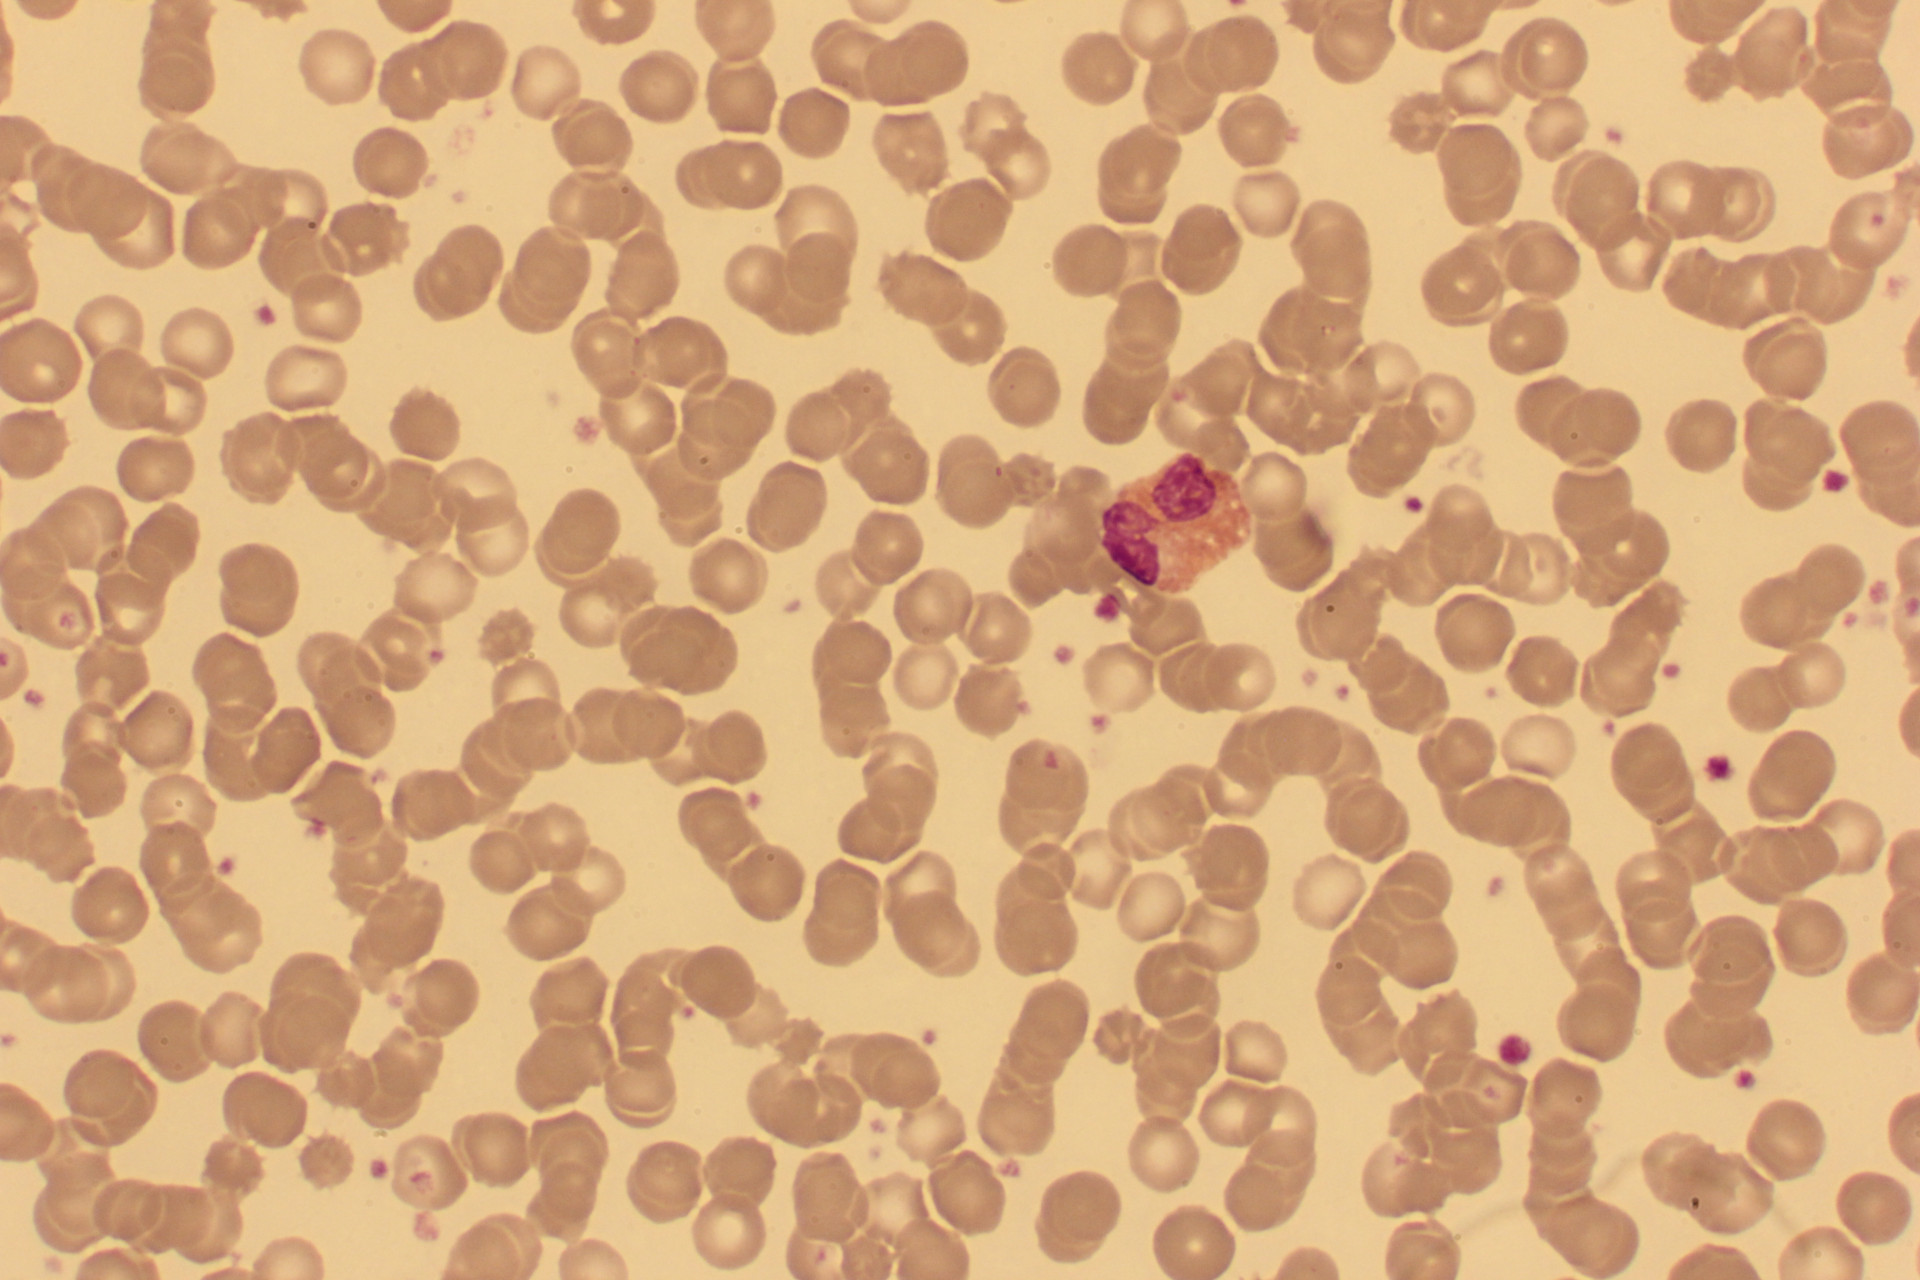
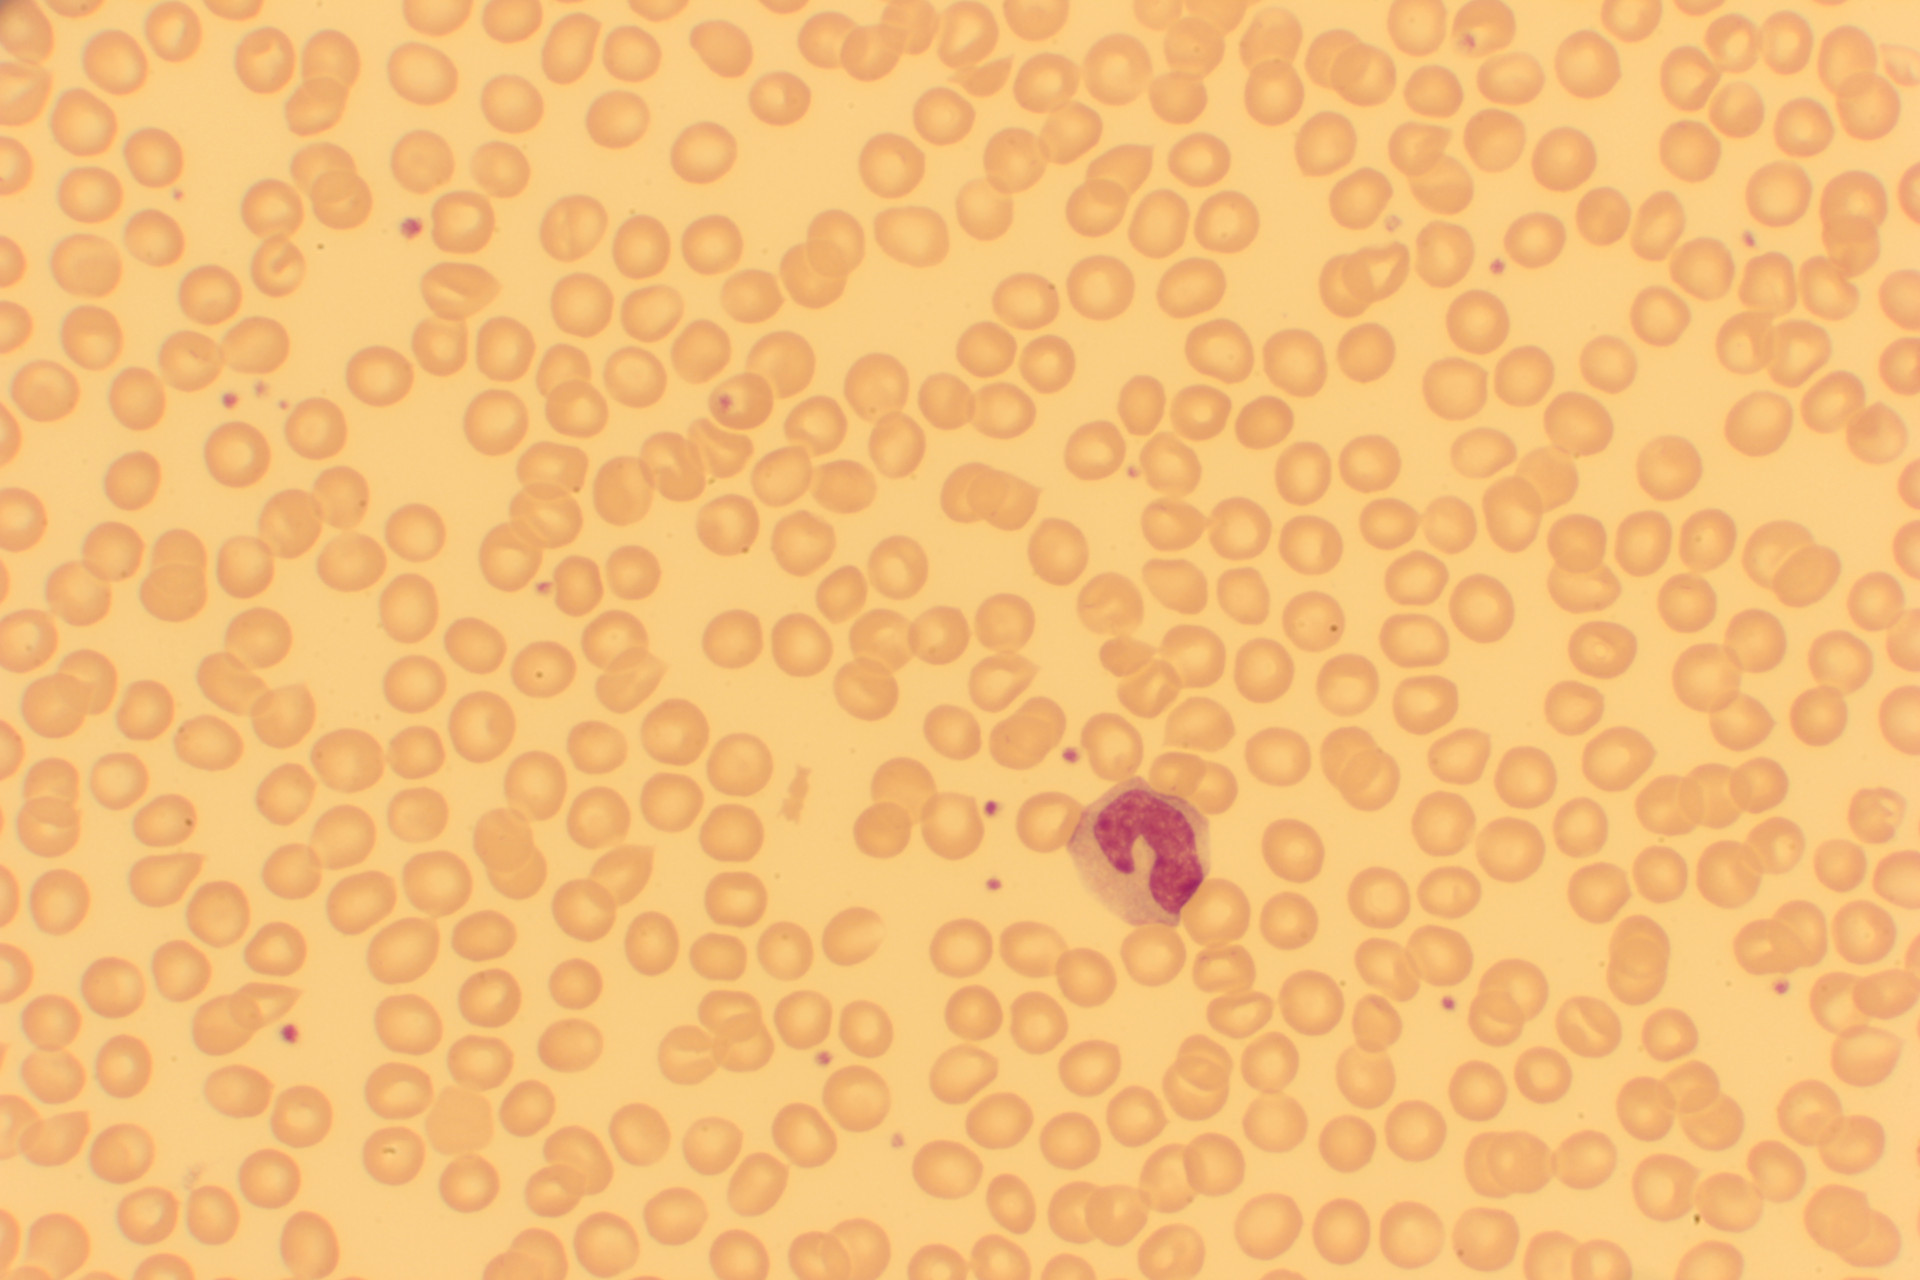
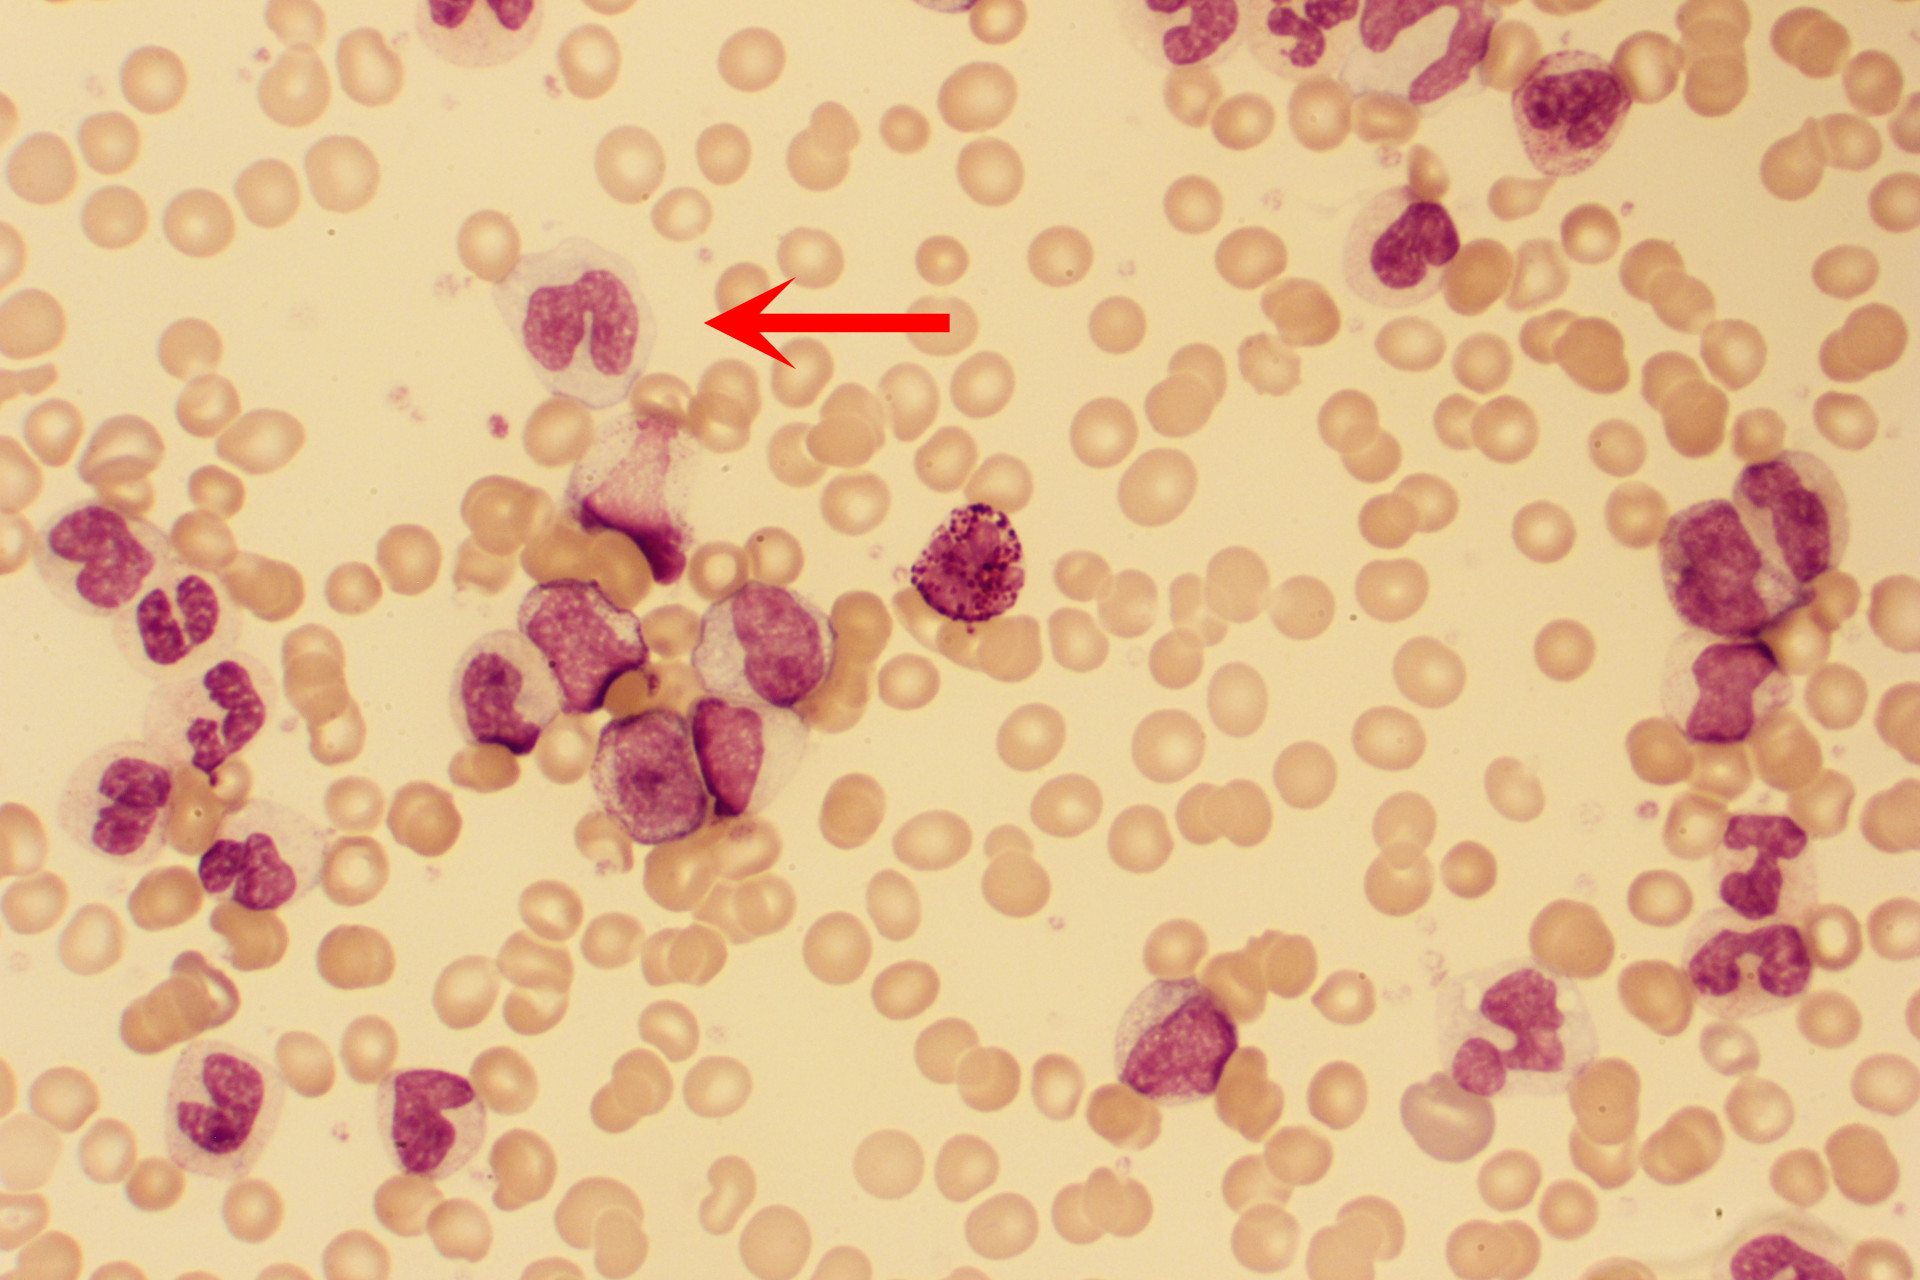

Testi: Kypsät solut
Testissä 15 kuvaa. Tunnista solu ja valitse annetuista vaihtoehdoista oikea. Ei aikarajoitusta.
 Oikein!
Oikein!
 Väärin!
Väärin!















Testissä 15 kuvaa. Tunnista solu ja valitse annetuista vaihtoehdoista oikea. Ei aikarajoitusta.